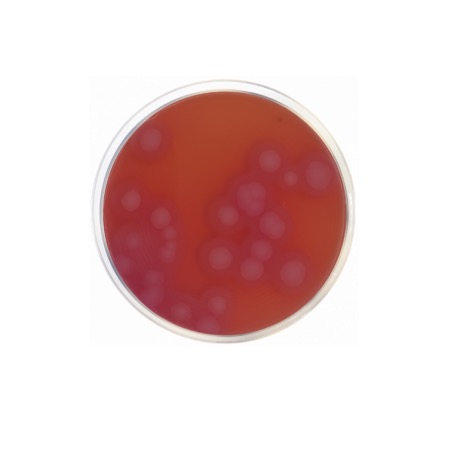
product
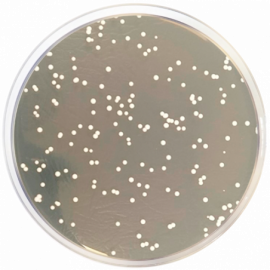
product
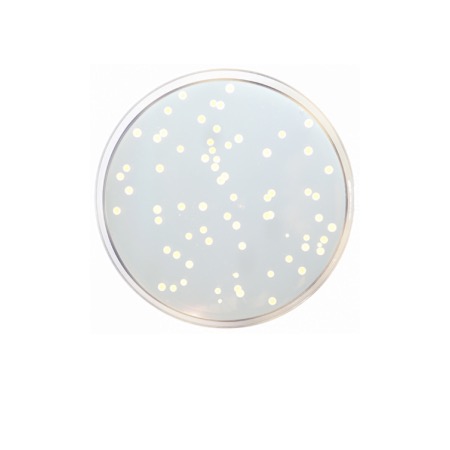
product

Condalab is a global leader in high-quality culture media, trusted by laboratories, research centers, and biotech companies around the world. Known for its scientific precision, rigorous quality standards, and innovative formulations, Condalab delivers reliable solutions that support everything from routine microbiology to advanced research applications.
On our website, you can explore the full Condalab catalog and order any products you need. Whether it’s a standard medium or a specialized formulation, we will source and deliver everything promptly and professionally. Choose the reliability of a world-class brand - place your order with confidence